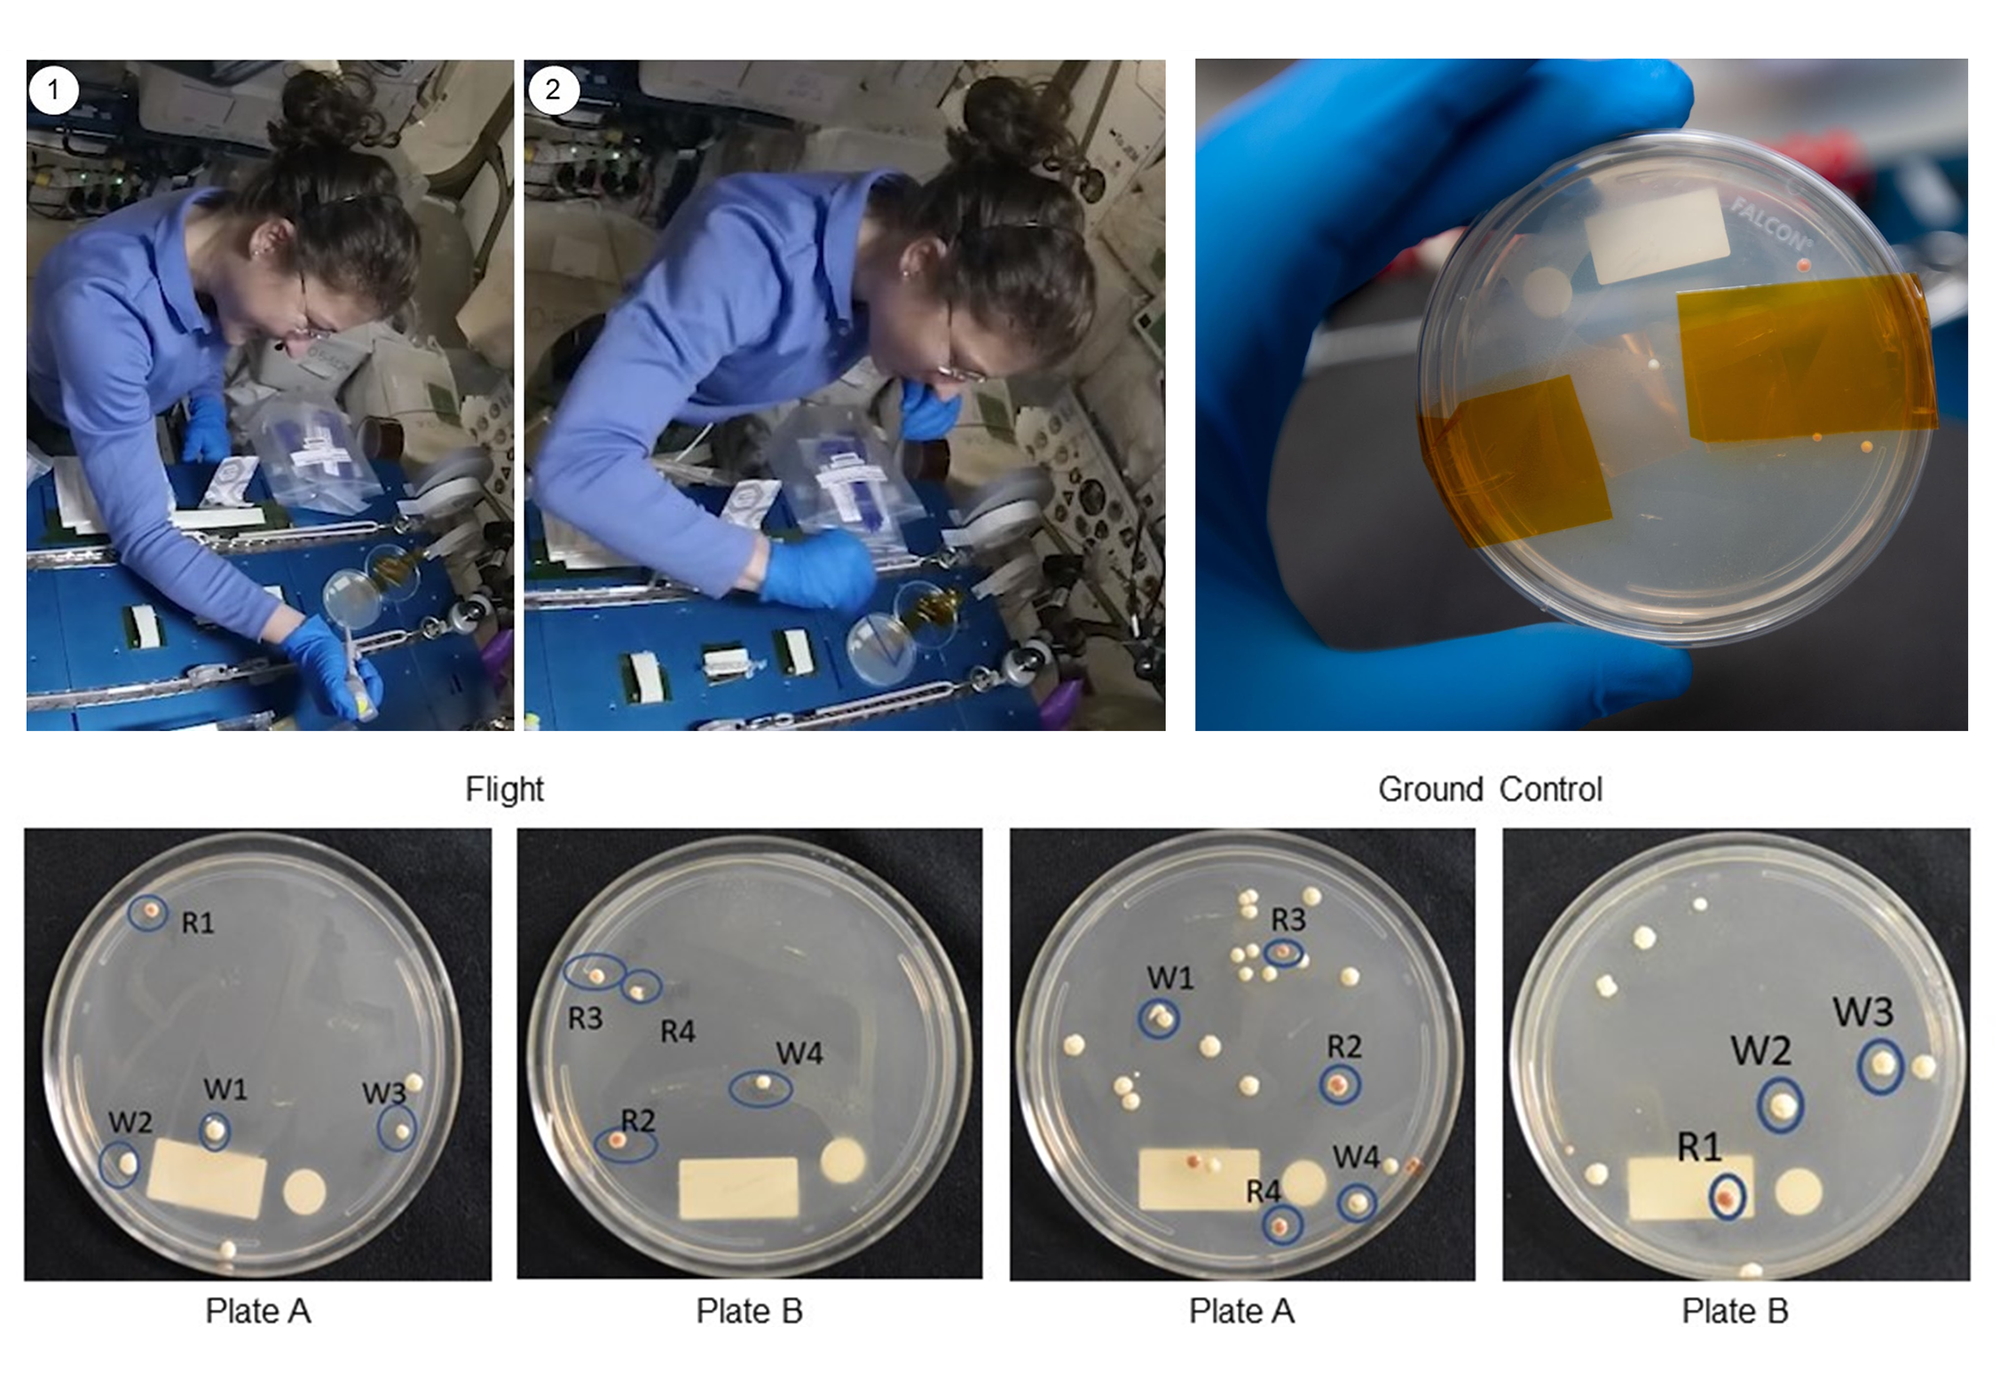
image

Prvo uspješno editiranje gena u svemiru
- Objavljeno u Znanost
Alati za CRISPR metodu editiranja gena po prvi puta su se koristili u svemiru. Istraživači na Međunarodnoj svemirskoj postaji editirali su kolonije kvasaca kako bi proučavali popravak oštećenog DNK, što predstavlja prvi korak ka iznalaženju načina za zaštitu astronauta od svemirskog zračenja.
CRISPR je jedno od najvećih znanstvenih otkrića prošlog desetljeća, koje omogućuje znanstvenicima jednostavno editiranje genoma u živim stanicama na "cut-and-paste" način.
Ta metoda editiranja gena mogla bi nam uvelike pomoći u borbi protiv raka, HIV-a, mišićne distrofije, dijabetesa i drugih bolesti, no do sada još nisu provođena istraživanja koja bi CRISPR primijenila na one ljude koji putuju svemirom.
Zbog niske gravitacije i visokih doza zračenja, astronauti doživljavaju gubitak mišićne mase i povećanje rizika od dijabetesa, kardiovaskularnih bolesti, hiperpermeabilnosti (sindroma propusnih crijeva), Alzheimera i raka.
U novoj studiji objavljenoj ovih dana u časopisu PLOS One, u okviru projekta "Genes in Space", znanstvenici su testirali ima li razlike u učinkovitosti CRISPR-a u u svemiru, pa su astronautkinja Christina Kock (slika gore) i njezini kolege metodu primijenili na editiranju genoma kvasca na ISS-u, kako bi usporedili učinke s kontrolnom grupom na Zemlji.
CRISPR sekvenca je bila dizajnirana za izrezivanje specifičnog DNK u kvascu pod nazivom "dvostruka pukotina" (DSB). Ovakvo oštećenje često nanose kozmičke zrake, a može biti posebno štetna. CRISPR je također uključivao i sekvencu koja bi koloniju obojila u crveno nakon što bi se popravila šteta, omogućujući znanstvenicima da jasno vide koje su kolonije uređene.
Neke kolonije na ISS-u postale su crvene u roku od šest dana od eksperimenta, što ukazuje da je uređivanje gena uspjelo, pa predstavlja prvu takvu demonstraciju učinkovitosti CRISPR tehnologije u svemiru.
Znanstvenici kažu da bi ovo mogli biti prvi koraci ka razvoju načina popravljanja DNK astronauta dok su u svemiru, kako bi ostajali čim zdraviji, što će biti od posebne važnosti kada će sve veću količinu vremena provoditi daleko od Zemlje prilikom dugih putovanja ili kolonizacija Mjeseca i Marsa.